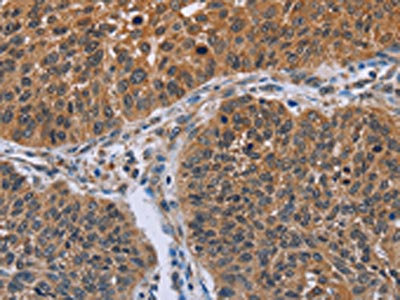

IHH Antibody
-
中文名稱:IHH兔多克隆抗體
-
貨號:CSB-PA226317
-
規格:¥1100
-
圖片:
-
The image on the left is immunohistochemistry of paraffin-embedded Human colon cancer tissue using CSB-PA226317(IHH Antibody) at dilution 1/30, on the right is treated with fusion protein. (Original magnification: ×200)
-
The image on the left is immunohistochemistry of paraffin-embedded Human lung cancer tissue using CSB-PA226317(IHH Antibody) at dilution 1/30, on the right is treated with fusion protein. (Original magnification: ×200)
-
-
其他:
產品詳情
-
Uniprot No.:
-
基因名:
-
別名:BDA1 antibody; HHG-2 antibody; HHG2 antibody; IHH antibody; IHH_HUMAN antibody; Indian Hedgehog antibody; Indian hedgehog homolog antibody; Indian hedgehog protein antibody; Indian hedgehog protein C-product antibody; Indian hedgehog protein N-product antibody
-
宿主:Rabbit
-
反應種屬:Human,Mouse
-
免疫原:Fusion protein of Human IHH
-
免疫原種屬:Homo sapiens (Human)
-
標記方式:Non-conjugated
-
抗體亞型:IgG
-
純化方式:Antigen affinity purification
-
濃度:It differs from different batches. Please contact us to confirm it.
-
保存緩沖液:-20°C, pH7.4 PBS, 0.05% NaN3, 40% Glycerol
-
產品提供形式:Liquid
-
應用范圍:ELISA,IHC
-
推薦稀釋比:
Application Recommended Dilution ELISA 1:2000-1:5000 IHC 1:50-1:200 -
Protocols:
-
儲存條件:Upon receipt, store at -20°C or -80°C. Avoid repeated freeze.
-
貨期:Basically, we can dispatch the products out in 1-3 working days after receiving your orders. Delivery time maybe differs from different purchasing way or location, please kindly consult your local distributors for specific delivery time.
-
用途:For Research Use Only. Not for use in diagnostic or therapeutic procedures.
相關產品
靶點詳情
-
功能:Intercellular signal essential for a variety of patterning events during development. Binds to the patched (PTC) receptor, which functions in association with smoothened (SMO), to activate the transcription of target genes. Implicated in endochondral ossification: may regulate the balance between growth and ossification of the developing bones. Induces the expression of parathyroid hormone-related protein (PTHRP).
-
基因功能參考文獻:
- TL1A modulated Rheumatoid arthritis-fibroblast-like synoviocytes migration and Indian hedgehog signaling pathway using TNFR2. PMID: 29748156
- Association of pathogenic variants in IHH with short stature with nonspecific skeletal abnormalities and a frequent cause of growth disorder, with a preliminary good response to rhGH. PMID: 29155992
- Studies suggest significance of other signaling aside from hedgehog in the pathogenesis of basal cell carcinoma (BCC) of the skin. PMID: 28574612
- Gorlin syndrome-derived induced pluripotent stem cells (iPSCs) expressed lower basal levels than control iPSCs of the genes encoding the Hh ligands Indian Hedgehog (IHH) and Sonic Hedgehog (SHH). PMID: 29088246
- Hedgehog pathway activation in T-cell acute lymphoblastic leukemia predicts response to SMO and GLI1 inhibitors. PMID: 27694322
- CLIC4 and Ihh could serve as biological markers for the progression, metastasis and/or invasiveness of pancreatic ductal adenocarcinoma. PMID: 28205343
- The serum levels of IHH and SHH were significantly higher in autistic subjects than those of control subjects. The findings support a correlation between SHH, IHH and BDNF in autistic children, suggesting their pathological role in autism. PMID: 26691363
- Our results show for the first time that Indian hedgehog does not cause extracellular matrix degradation in healthy ex vivo cartilage or in the presence of IL-1beta PMID: 26705100
- The Annexin a2 Promotes Development in Arthritis through Neovascularization by Amplification Hedgehog Pathway. PMID: 26963384
- Studies indicate that the hedgehog (Hh) signaling pathway has become one of the most studied potential therapeutic targets in hematological malignancies. PMID: 24991722
- Findings demonstrated that Ihh promotes human cartilage endplate degeneration. PMID: 25958162
- endogenously produced IHH is playing a critical role in regulating hBMSC chondrogenesis. PMID: 25519748
- Duplication of the upstream IHH regulatory region and a correlation between the phenotype and the implicated regulatory regions in a family with craniosynostosis Philadelphia type. PMID: 25692887
- Data show that the Hh (Hedgehog) signalling pathway mediates chemoresistance of BCSCs (breast cancer stem cells) and contributes to the outcome in breast cancer patients. PMID: 26201092
- Data suggest that hedgehog (HH) signaling through transcription factors GLI1 and GLI2 could be required for the maintenance of pregnancy. PMID: 25888497
- Studies indicate that activation of the hedgehog (Hh) signaling pathway has been observed in several cancer types, including ovarian cancer. PMID: 23303278
- Gene transfer of indian hedgehog protein results in chondrogenic induction of mesenchymal stem cells. PMID: 22817660
- Data indicate that neutralizing hedgehog antibody MEDI-5304 represents a potent dual hedgehog inhibitor suitable for patients with tumors harboring elevated levels of sonic hedgehog (SHH) or indian hedgehog (IHH). PMID: 24344235
- Indian Hedgehog, a critical modulator in osteoarthritis, could be a potential therapeutic target for attenuating cartilage degeneration disease. PMID: 24844414
- Increased Ihh is associated with the severity of osteoarthritis cartilage damage. Elevated Ihh content in human knee joint synovial fluid correlates with early cartilage lesions. PMID: 24786088
- Data indicate that overexpression of Indian hedgehog (Ihh) signaling promotes abnormal chondrocyte differentiation in enchondral ossification and enhances bone formation in cervical ossification of the posterior longitudinal ligament (OPLL). PMID: 23883825
- We further indicated that SHH and IHH were highly expressed in metastatic tumors PMID: 23468532
- Studies indicate that upregulation of Hedgehog protein has been found in tumor-associated stroma and associated with vascularization and excessive stromal expansion can limit intratumoral drug delivery. PMID: 23575478
- Hedgehog signaling regulates hypoxia induced epithelial to mesenchymal transition and invasion in pancreatic cancer cells via a ligand-independent manner. PMID: 23786654
- Data indicate that compounds 7 and 9 (diterpene) showed cytotoxicity against cancer cell lines in which hedgehog (Hh) signaling was aberrantly activated. PMID: 23403897
- Data indicate that analysis of public microarray data suggests that PBOV1 activation in tumors could be dependent on the Hedgehog signaling pathway. PMID: 23418531
- Results suggest that hypoxia-induced increase of Smo directly contributes to the proliferation of pancreatic ductal adenocarcinoma (PDAC) cells through a hedgehog/Gli1-independent pathway. PMID: 22486854
- Intra-articular injection of human mesenchymal stem cells (MSCs) promote rat meniscal regeneration by being activated to express Indian hedgehog that enhances expression of type II collagen. PMID: 22750747
- A missense mutation in IHH gene is observed in an individual affected by brachydactyly type A1. PMID: 22406540
- A large duplication involving the IHH locus mimics acrocallosal syndrome PMID: 22234151
- Activation of Indian hedgehog promotes chondrocyte hypertrophy and upregulation of MMP-13 in human osteoarthritic cartilage. PMID: 22469853
- Ihh-induced Nkx3.2 degradation requires Wnt5a, which is capable of triggering Nkx3.2 degradation PMID: 22507129
- Studies indicate that pathways of Hedgehog (Hh), Wnt and Notch, which regulate development during embryonic life and somatic stem cells (SCs) in the adult organism, can be reactivated in malignancies and support tumor-initiating cells (TIC) scompartment. PMID: 22123293
- Studies indicate that IHH is required for normal chondrocyte proliferation during both embryonic and postnatal growth. PMID: 21642379
- Nuclear and cytoplasmic endometrial expression of Indian hedgehog is decreased in women with endometriosis. PMID: 21640343
- VLDL carries Ihh throughout the body in mammals PMID: 20839884
- the observed duplications lead to a misexpression and/or overexpression of IHH and by this affect the complex regulatory signaling network during digit and skull development. PMID: 21167467
- This data confirms genetic heterogeneity in Brachydactyly A1 (BDA1) and demonstrates that mutations upstream of IHH can result in BDA1. PMID: 20683927
- The temporal increase in endometrial IHH during the secretory phase, and their modulation by CDB-2914 suggests progestin role in endometrial differentiation and implantation. PMID: 20881264
- down-regulation of indian hedgehog expression as a result of hypermethylation, may be an early event in colorectal carcinogenesis PMID: 20854074
- Methylation analysis revealed that IHH promoter was hypermethylated in colon cancer cell lines. PMID: 19856079
- Indian hedgehog protein was detected in cystic tubules within human dysplastic kidneys; these molecules modify severity of this congenital malformation. Hedgehog signaling may be important stimulus for renal cyst formation. PMID: 20007344
- describes cloning of human IHH PMID: 7720571
- Data show that all of the BDA1 mutations occur in a restricted area of the N-terminal active fragment of the IHH. PMID: 19277064
- expression is preserved in the growth plate of human fetuses affected with fibroblast growth factor receptor type 3 activating mutations PMID: 12368206
- novel mutation causes brachydactyly type A1 PMID: 12384778
- A novel missense mutation in the IHH gene mapping to chromosome 5 has been identified identified in all patients of a brachydactyly type A1 family. PMID: 12525541
- Homozygous mutations in this gene cause acrocapitofemoral dysplasia, an autosomal recessive disorder with cone-shaped epiphyses in hands and hips. PMID: 12632327
- model of the interactions between beta-catenin and hedgehog signaling in the epidermis in which SHH promotes proliferation of progenitors of the hair lineages whereas IHH stimulates proliferation of sebocyte precursors PMID: 12917489
- a wide range of digestive tract tumours, including most of those originating in the oesophagus, stomach, biliary tract and pancreas, but not in the colon, display increased Hh pathway activity, which is suppressible by cyclopamine, a Hh pathway antagonist PMID: 14520411
顯示更多
收起更多
-
相關疾病:Brachydactyly A1 (BDA1); Acrocapitofemoral dysplasia (ACFD)
-
亞細胞定位:[Indian hedgehog protein N-product]: Cell membrane; Lipid-anchor; Extracellular side.; [Indian hedgehog protein C-product]: Secreted, extracellular space.; Cell membrane.
-
蛋白家族:Hedgehog family
-
組織特異性:Expressed in embryonic lung, and in adult kidney and liver.
-
數據庫鏈接:
Most popular with customers
-
YWHAB Recombinant Monoclonal Antibody
Applications: ELISA, WB, IHC, IF, FC
Species Reactivity: Human, Mouse, Rat
-
Phospho-YAP1 (S127) Recombinant Monoclonal Antibody
Applications: ELISA, WB, IHC
Species Reactivity: Human
-
-
-
-
-
-
VDAC1 Recombinant Monoclonal Antibody
Applications: ELISA, WB, IHC
Species Reactivity: Human, Mouse, Rat